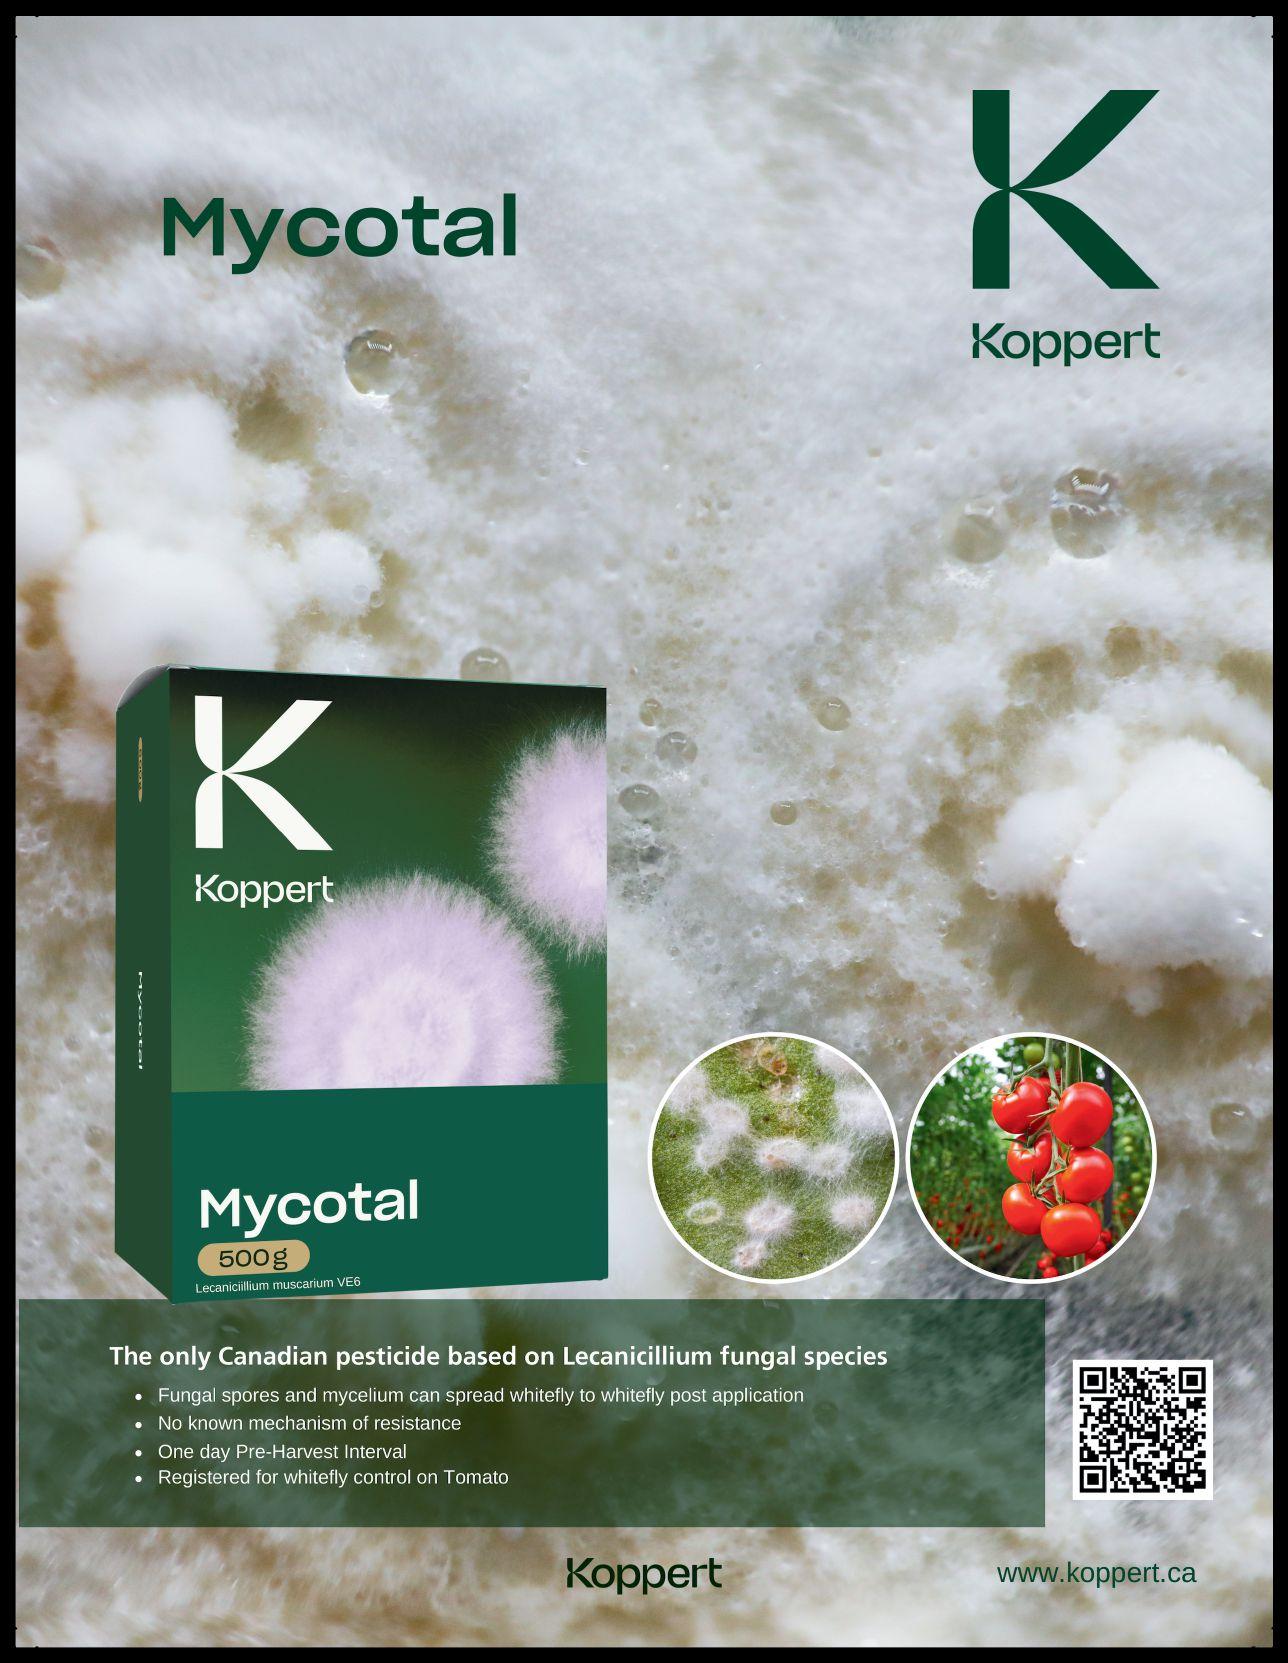

Perennial powerhouses
Examining results from the University of Guelph’s 2023 flower trials. By Rodger Tschanz

Plant
Understanding
BY AMY KOUNIAKIS
MOHYUDDIN MIRZA

![]()





Perennial powerhouses
Examining results from the University of Guelph’s 2023 flower trials. By Rodger Tschanz

Plant
Understanding
BY AMY KOUNIAKIS
MOHYUDDIN MIRZA

As we progress through one of the busiest seasons of the year for the greenhouse industry, I urge readers to keep an eye out for those individuals in the sector who are making a positive impact. If you see someone out there pushing the needle in the right direction, we want to hear about them! Remember: nominations for our Top 4 Under 40, sponsored by Paul Boers Manufacturing and Prins Greenhouses, and our Grower of the Year awards are now open and we want to know who you think the best and brightest in the biz are (nominations close May 10). Once selected, winners will be honoured at our Grower Day event on June 18.
Growers also get an update on the Tomato Brown Rugose Fruit Virus (ToBRFV) from researchers from Agriculture and Agri-food Canada (AAFC) and the Ontario Ministry of Agriculture, Food and Rural Affairs (OMAFRA) on page 12. In this piece, growers will learn about developments in ToBRFV resistance and best management approaches.
Additionally, on page 20, researchers from Niagara College provide an in-depth update on battling cannabis and rice root aphids. Scott Golem and Sebastien Jacob contribute their expertise on these pests and their impact on cannabis cultivation in addition to offering some hard-earned insights on managing them.
They say April showers bring May flowers and, in this issue, we deliver on that promise with a look at the results of the University of Guelph’s perennial flower trials in 2023. Rodger Tschanz, who is the driving force behind this extensive trial, details some of the results and shares
“We want to know who you think the best and brightest are.”
While you consider possible nominees for this year’s award programs, perhaps you’ll want to take a moment to read this month’s cover story about CosMic Plants. This family-run orchid operation in Beamsville, ON, is celebrating its 20th anniversary. I had the opportunity to tour one of the company’s greenhouses this past winter and was impressed by the scale and precision of this operation. Learn more about the van Steekelenburg family and their long-held tradition of greenhouse growing on page 8
On page 26 take a moment to read some of Dr. Mohyuddin Mirza’s advice for crop management in the greenhouse, specifically ornamental and bedding plant crops, during this busy season. He drives home the point that understanding the unique needs of a particular crop is the key to successful cultivation and can save a lot of time and money.
what he’s learned about these plants over the years he’s been working with them. Check out his article on page 30.
And finally, in this issue we share some of the data from our annual Grower Survey on page 16. See for yourself how the industry is faring through the insights of those on the frontline. One again, your participation in this endeavour is so very much appreciated.
Until next time, have a safe and healthy season and don’t forget to get your nominations in!
GST - #867172652RT0001 Occasionally, Greenhouse Canada will mail information on behalf of industry-related groups whose products and services we believe may be of interest to you. If you prefer not to receive this information, please contact our circulation department in any of the four ways listed above. No part of the editorial content of this publication may be reprinted without the publisher’s written permission. ©2024 Annex Business Media. All rights reserved. Opinions expressed in this magazine are not necessarily those of the editor or the publisher. No liability is assumed for errors or omissions. All advertising is subject to the publisher’s approval. Such approval does not imply any endorsement of the products or services advertised. Publisher reserves the right to refuse advertising that does not meet the standards of the publication.


Your journey in advanced greenhouse cultivation begins here. Partner with our expert agronomists and horticultural specialists for a seamless experience.



Our dynamic solution enables unlimted zoning to grow an infinite variety of crops.
Our SUNaaS platform delivers custom spectrums and advanced data to optimize growth.
Automatic dimming delivers the right amount of light all the time to lower energy costs.
Experience the ease of technology with our e icient setup and expert guidance, tailored to your growth goals. Your success, our commitment:
Our agronomists, horticultural and technical experts are on call and SUNaaS monitoring fixtures 24/7.
The average value of Canadian farmland continued its steady climb in 2023, increasing by 11.5 per cent, slightly less than the 12.8 per cent increase reported in 2022, according to the latest FCC Farmland Values Report.
In Ontario, average farmland values increased by 10.7 per cent in 2023, following gains of 19.4 per cent in 2022 and 22.2 per cent in 2021.
The highest average provincial increases in farmland values were observed in Saskatchewan, Quebec, Manitoba and Ontario, with double-digit average increases of 15.7, 13.3, 11.1 and 10.7 per cent, respectively. Four provinces

had single-digit average increases and were below the national average at 7.8 per cent in Nova Scotia, 7.4 per cent in Prince Edward Island, 6.5 per cent in Alberta and 5.6 per cent in New Brunswick.
British Columbia recorded an average decline of 3.1 per cent, yet the province has the highest farmland values on average.
There were an insufficient number of publicly reported sales in Newfoundland and Labrador, Northwest Territories, Nunavut and Yukon to fully assess farmland value trends in those regions. (Source: Farm Credit Canada)
One Floral Group’s greenhouse propagation team will be conducting their first trial with LED grow lights using Sollum’s smart, fully dynamic LED solution.
Form more than 10 years, One Floral Group has been propagating a variety of flower and vegetable crops in
Leamington, ON, to be distributed to clients across North America. With a particular focus on developing floral solutions, One Floral has decided to conduct a trial with LEDs to bring a new level of efficiency in their operations and support the cultivation
The Dramm Corporation announced recently their partnership with CE-Line to provide in-line nutrient testing of irrigation water across North America. CE-Line is a laboratory quality, nutrient analysis system that automatically samples water throughout the day. This in-line testing solution provides accurate data within an hour, eliminating the wait for test results from a remote laboratory. Sample results are securely stored in the cloud with APIs available to connect to climate control and fertigation systems. This connectivity allows for automated optimization of nutrient levels in real-time.
The CE-Line system schedules testing of different sources throughout the day, measuring both macro and micronutrients. NH4, K, Na, Mg, Ca, Cl, NO3, SO4, HCO3, PO4 Fe, B, Zn, Mn, Mo, Cu can all be tested. CE-Line has automated the laboratory process of capillary electrophoresis to accurately measure these different nutrients. Each unit can take up to eight different samples per day, from multiple sources, using a supply of reagents and cleaning solutions. (Source: DRAMM corporation)
of an increasing variety of products. For this trial they are using Sollum’s fully dynamic LED lighting solution, which offers a flexible and efficient solution to grow a variety of crops using a single technology, and with an unmatched precision in terms of intensity and
spectrum.
Floriculture stats update: April 2024
In January 2024, the combined total inflation adjusted exports were $59.1 million.
“As one of Ontario’s largest propagators of flower varieties, we feel it is time to take the next step for our business and explore new technologies,” says Ryan Selwood, Maintenance Manager for One Floral Group. (Source: Sollum Technologies) (SOURCE:
In 2023, household consumption of Garden products, plants and flowers saw a 3.21% decrease over 2022, but a 0.43% increase over the 3-year trailing average (2020-2022).







CosMic Plants mark 20 years of orchid majesty as it welcomes a new era of innovation and precision growth
BY AMY KOUNIAKIS
For two decades, CosMic Plants has come close to perfecting the art of growing orchids and as the company enters a new chapter, the family at the heart of this operation remains dedicated to this age-old tradition but with an emphasis on meeting the challenges of today’s business landscape through innovation and creativity.
When the business launched in 2004 in the heart of the Niagara Region in Ontario, brothers Neil and Mike van Steekelenburg set out to populate the world with breathtaking Phalaenopsis, a plant that was only just starting to gain popularity in North America at the time.
“We weren’t growing them (in our greenhouse) in the Netherlands,”
recalls Neil (short for Cornelis), who emigrated to Canada with his family in 2004, the same year that CosMic was incorporated. “We wanted to try something else and this is a beautiful crop that lasts a long time.”
Neil says that they were drawn to the exotic beauty of orchids and were fascinated by the plant’s complexities. They learned early on that this crop wasn’t for the faint at heart: from propagation to finished product is about 18 months.
“We didn’t start selling (orchids) until 2006,” Neil remembers, adding that at the time, they were only using about half of the production space in the nearly 60,000 sq.-ft. facility he and his brother started out in.
Those first few years of trial and
error and smaller yields paid off in that it gave the brothers an opportunity to hone their skills with the crop and familiarize themselves with the marketplace. That well-earned expertise propelled them into becoming one of Canada’s largest orchid producers.
Today, CosMic Orchids are shipped across Canada and into the U.S., even as far as California. The company operates out of two production facilities in Niagara and propagates, grows and ships upwards of 1.5 to 2 million Phalaenopsis annually.
It’s a level of success that Connor van Steekelenburg hopes to build on as he takes the reins at CosMic. Connor, son of Neil, bought out and took over for his uncle Mike in late 2023.
“I worked in the greenhouse as a teen but I was encouraged by my dad to branch out,” says Connor of his decision to pursue a civil engineering degree. “I was always still interested in the greenhouse and how it ran.”
This is why, when it seemed a career in his chosen scholarly field wasn’t going to be a good fit, Connor jumped at the chance to get back into the family business on the production line. Not long after, in early 2020, the younger van Steekelenburg, with a mind to learning more about the nature of the commercial greenhouse business, travelled back to the Netherlands to work in a state-of-the-art orchid greenhouse.
“That experience really lit a fire in me. I wanted to see if what they were doing there could be done here,” he says.
He would have his chance to satisfy this curiosity as COVID-19 cut short his plans in Europe and he returned home to

help his family navigate the pandemic.
During those years, Connor helped run the retail portion of the business, establishing a curbside pick-up process. He also carved out a separate role for himself on the production side of things as a production and facilities maintenance manager.





CosMic is one of Canada’s biggest growers of Phalaenopsis, growing upwards of 1.5 to 2 million plants annually.
“I was constantly looking for ways to improve and increase efficiencies,” Connor says. “I wanted to be a part of moving the company forward.”
Water quality and sustainable practices soon became one of Connor’s top priorities. “We really tried to get us to a place of reduced risk,” he says of the push to implement various sanitation systems and the installation of new flushing lines. He supervised a significant expansion of the company’s greenhouses and has helped usher in an era of precision growing with the introduction of a variety of technologies that monitor the health of the crop. CosMic credits its close connection with the Hoogendoorn team in helping them achieve more granular control of this high-input crop. Connor also recently oversaw the replacement of 900 older light fixtures with LED technology.
Other sustainable efforts include the company’s integrated pest management (IPM) program, which is 99 per cent chemical free. According to Neil, chemicals are used as a last resort and only for the odd hot-spot treatment. The company also uses natural gas as a heat source for high-efficiency boilers, and the exhaust CO2 is cooled down by economizers and used in the greenhouses to enhance plant growth.
These efforts have not gone unnoticed. In the summer of 2023, CosMic was the
first orchid grower in Canada to achieve MPS-A environmental certification.
As high-tech and precise as the production of Phalaenopsis has gotten at CosMic, the heart of the business is still powered by its people. This is why, from day one, CosMic has insisted that its employees spend time working in each area of the business in order to learn its nuances and challenges. This is also because during the busy seasons, it’s an all-hands-on-deck situation on the production floor.
“We have involvement from top to bottom,” said Neil. “It creates team spirit, and it can be a lot of fun.” That positivity and sense of empowerment translates into lower employee turnover and a high rate of return for temporary workers. It’s also led the company to explore ways to empower customers similarly.
Later this year, CosMic aims to launch an online platform to school users on the products they grow. The platform, called ‘Orchid University’, aims to provide retailers and their customers with the most up-to-date information on orchid care and production.
RIGHT
Check it out: CosMic was featured in Greenhouse Canada in 2008! See for yourself how things have changed.
“It will provide a high level of product knowledge because we feel it is extremely important to educate the frontline marketplace,” Neil said, adding they feel providing this level of service takes some of the intimidation out caring for orchids.
With all these changes afoot, Connor remains steadfast in his dedication to maintaining the tradition of producing healthy, high-quality crops established by his father and uncle.
“We’re still hashing out what the future will hold, but we have a pretty strong foundation to build on,” he says.
As for Neil, his days at the greenhouse are anything but numbered.
“I still have a lot of fun doing this,” he says with that always present, sheepish grin of his. “I’ll be here as long as they want me.”

Learn, explore, discover, grow, and connect at Cultivate—the event for green industry professionals to advance business, develop teams, and build your bottom line.



BY JONATHAN S. GRIFFITHS, CARA MCCREARY, GENEVIÈVE MARCHAND, AND AIMING WANG
Tomato brown rugose fruit virus (ToBRFV) has devastated greenhouse tomato production globally since its emergence in 2014 in Israel and Jordan. The virus spreads rapidly through greenhouses due to its ease of mechanical transmission combined with the high degree of crop maintenance required, and can destroy thousands of plants in weeks. This virus has forced substantial changes to how tomatoes are produced and has significantly increased costs of production. The seed industry has responded with the rapid development of tolerant and resistant varieties while producers have worked to improve biosecurity protocols. Yet ToBRFV still circulates worldwide, while the stability and long-term performance of resistance
ABOVE
genes remains uncertain. Here we summarize recent developments in ToBRFV resistance and discuss best management approaches.
ToBRFV prevention and mitigation will likely continue to be vital until stable and durable resistance is identified and widely available. Multiple commercial resistant varieties are available from different seed suppliers, with varying classification of resistance and levels of effectivity. The International Seed Federation (ISF) defines three types of plant-pathogen interactions including:
• Susceptible as the inability to restrict growth
This image shows leaf mosaic and mottling, which are typical symptoms of early ToBRFV infection.
resulting in symptom development.
• Intermediate Resistance (IR) as the ability to restrict pathogen growth.
• High Resistance (HR) as the ability to restrict pathogen growth to a high degree.
(Source: https://worldseed.org/ document/definitions-of-the-terminologyplants-pests-v-o-seed-industry-2022/)
In addition to ToBRFV, other major tobamoviruses that severely affect tomato production are Tobacco mosaic virus (TMV) and Tomato mosaic virus (ToMV). Three single resistance genes including Tm-1, Tm-2 and Tm-22 provided longstanding effective resistance to other tobamoviruses like TMV and ToMV Tm-1 and Tm-2 are not used as widely as Tm-22. This is because the former two only provide strainor pathotype-specific resistance, whereas Tm-22 confers durable and broad-spectrum resistance to all tobamoviruses, until the emergence of ToBRFV. Unfortunately, all three resistance genes including Tm-22 are ineffective against ToBRFV. Despite this deficiency, these genes are still important for tomato production moving forward. Tm-22 is still highly effective against TMV and ToMV and without this gene we may see these viruses re-emerge. Although Tm-1 alone is ineffective against ToBRFV, recent publications have demonstrated that this gene combined with another unknown resistance gene, can provide resistance to ToBRFV, suggesting it could be important for the future of resistance. Trying to restore Tm-22 functionality against ToBRFV is another major research area. Other ToBRFV resistance germplasms have also been identified in wild tomato relatives, but the identity of the resistance genes involved and how they prevent ToBRFV infection are yet to be studied. The resistance and tolerant varieties currently being sold by seed suppliers are most likely using one or more of the genes previously identified from wild relatives. Due to commercial protection of and intellectual property, not much information is released regarding which resistance genes are used, how strong the resistance or tolerance trait is, or how durable the resistance and tolerance will be. A better understanding of how resistance genes work, both old and new, can help to improve current resistance strategies.
In order to eliminate the threat of ToBRFV, further research is required to identify and optimize performance
of these lines, and breeding for new resistant varieties is a time-consuming laborious process. One possible step is to stack multiple ToBRFV resistance genes together. Plants with two resistance genes could perform better than just one, assuming they operate through independent mechanisms. For now, commercially available lines should be grown with attention towards reducing opportunities for the virus to break resistance. Otherwise, ToBRFV may continue to evolve and escape resistance.
ToBRFV management is best broken down into three major areas: preventative actions, monitoring, and mitigation once ToBRFV has been detected. Once ToBRFV has been detected in a greenhouse eradication can be extremely challenging in the long-term. Prevention is paramount in maintaining healthy and profitable greenhouse production. It is imperative to conduct a thorough clean out between crops and practice diligent sanitation throughout production.



ABOVE
Prevention: Introduction of ToBRFV can be partially mitigated through bulk screening of seeds and seedlings prior to transplanting into clean greenhouses, but this will not guarantee that there are no infected seedlings and should be followed with monitoring programs. Greenhousewide monitoring approaches like regular screening of bees or nutrient solutions could also be deployed and can alert growers up to two weeks earlier than visual inspections but can create added costs. Because of the risks associated with humans spreading ToBRFV, visitor and employee hygiene should be a primary focus. Regular cleaning and sanitation of high touch areas like door handles, crates, forklifts, broom handles, keyboards and more can reduce the risk of introduction and spread.
Monitoring: Monitoring through visual inspections can help with detection but can be unwieldy due to the sheer number of plants grown in modern commercial greenhouses. Usually, the best approach includes consistent visual inspections of plants for symptoms followed by confirmation of infection using molecular testing. All employees should be aware of symptoms and a plan for immediate reporting should be in

place. Of particular importance when monitoring resistant lines is identifying symptomatic plants early and taking actions quickly. Whole greenhouse monitoring could be performed through sampling of nutrient solutions or even regular sampling of bees could help in early detection of ToBRFV.
Mitigation: Once ToBRFV has been detected in a greenhouse, complete eradication is unlikely without crop destruction and a thorough clean out. Thus, growers will face a major decision: to continue with the crop and try to manage the outbreak or remove the crop and start over. These decisions are usually financially motivated and often depend on when in the crop cycle the infection occurs. Letting ToBRFV outbreaks continue will only increase the relative amount of the virus in the environment and could make it more difficult to keep future crops clean. Removing ToBRFVpositive plants (roguing), quarantining infected areas, or eliminating large areas can help slow the spread of the virus and reduce opportunities for resistance breaking outbreaks.
Replanting into ToBRFV contaminated growing medium is not recommended, as this could lead to repeated outbreaks
even when using resistant or tolerant varieties. Unless the varieties are immune, exposure of these lines to high levels of ToBRFV puts pressure on the virus to find ways to survive increasing the likelihood of ToBRFV breaking resistance. Crop rotations and mixing in non-hosts such as cucumbers could also be beneficial towards eliminating ToBRFV.
Currently, there is no simple answer for growers when they face these issues. Until new durable sources of resistance to ToBRFV have been demonstrated in commercial production that have broad preventative control of ToBRFV, industrywide mitigation efforts are required. Identification and development of novel sources of resistance via state-of-art molecular tools and introduction of these novel resistance genes into tomato varieties using advanced biotechnology are vital for sustainable tomato production.
Jonathan S. Griffiths, Geneviève Marchand, and Aiming Wang are research scientists with Agriculture and Agri-Food Canada. Cara McCreary is a Greenhouse Vegetable IPM specialist with the Ontario Ministry of Agriculture, Food and Rural Affairs.
Neudorff North America is an innovative leader in ecologically responsible pest solutions for nursery and greenhouse growers, farmers and turf professionals.
Our effective and affordable solutions for disease, insect pests, pest slugs and snails have limited impact on applicators, and the environment. They are an important part of integrated pest management programs.
Powerful disease protection for your greenhouse vegetable and ornamental crops with a fraction of the copper found in other copper fungicides.
Fast-acting insecticidal soap. Controls aphids, mites and whiteflies on ornamentals, herbs, spices, vegetables, including cannabis. Effective as a cutting dip to control whitefly nymphs.
A summer and dormant oil. Controls all life stages of insects and mites. Suppresses powdery mildew of greenhouse ornamentals, fruit, vegetables and cannabis grown indoors.
Fact acting. Controls moss, algae and liverworts in and around greenhouses.
A durable pelleted iron phosphate bait. Provides excellent protection of greenhouse crops from slugs and snails.
A durable, fast-acting pelleted spinosad bait that is active against a wide range of ants in greenhousegrown vegetables and ornamentals.
Inside and outside. Neudorff protects.






BY AMY KOUNIAKIS
The results of Greenhouse Canada’s 2024 Grower Survey are in and they offer an intriguing snapshot of the Canadian greenhouse industry for 2024 and beyond. Before digging into some of this year’s results, it must be noted that the results of this survey should be considered informal and anecdotal.
Canadian growers across the country participated in this year’s Grower Survey, with more than 50 individuals sharing insights on their business. Growers were asked to identify the crops their operation primarily produced. Approximately 32 per cent of respondents indicated they mainly produced edible crops (vegetables and fruits) while 22 per cent indicated flowers as their main product. Fourteen per cent of participants indicated that both flowers and edibles were a primary focus of their greenhouse production. Approximately 32 per cent of respondents grew something other than vegetables and flowers (crops mentioned included trees, shrubs and perennials; young plants, cuttings and grafts).

ABOVE
Participants of Greenhouse Canada’s 2024 Grower Survey were asked to share a word or two about what keeps them up at night as it pertains to their business. This is a visualization of the collected responses.
Those who participated in this year’s survey also represented operations in a range of sizes. The majority, 40 per cent, claimed production space of less than 10,000 sq.-ft., while 32 per cent indicated space between 10,000 and 50,000 sq.-ft. An additional 28 per cent of participants operated in more than 50,000 sq.-ft.
Growers were also asked to describe what market trends most influence crop selection and production strategies. Most survey participants, 42 per cent, indicated that
year-round availability of plant material was the most important factor influencing crop selection, while 22 per cent of respondents cited the ‘organic and locally grown’ trend as being an important factor. Exotic or speciality crops helped to influence 20 per cent of respondents as it
comes to crop selection.
When respondents were asked to indicate what ‘other’ marketing trends influenced their planning, some of the responses indicated that zone hardiness, taste, and consumer preferences were driving forces.
Far and away the biggest challenge for greenhouse growers in 2023 was the rising costs of production and doing business. Approximately 76 per cent of survey respondents (who were asked to choose all that apply from a list of challenges)





Wholesale to retailers
indicated that rising costs were indeed their biggest challenge. Labour shortage was the second biggest challenge for growers in 2023, with approximately 32 per cent of respondents indicating this. Issues caused by weather and natural disaster was another big challenge for 18 per cent of survey respondents and this was followed very closely by ‘regulatory issues’ that posed significant challenges for 16 per cent of participants.
While the cost of business continues to climb, the majority of survey respondents, 34 per cent, indicated that they will be increasing the cost of their products by less than five per cent in response. Twenty-four per cent said they would be considering a five to nine per cent price hike, while another 18 per cent noted that they will not be changing the price of their products. Ten per cent of respondents expect to hike prices by more than 10 per cent even as four per cent said they were considering reducing prices.
Growers were also asked to consider what they see as their biggest challenge in the next three to five years. At 36 per cent, energy prices were seen as the biggest challenge for the near term, followed closely by the cost and availability of supplies (26 per cent and rounding out the top 3 is wage increases (16 per cent).
On a positive note, there are plenty of reasons for optimism in the coming years. According to our survey, automation and
WHICH INVESTMENTS DO YOU PLAN TO MAKE IN THE NEXT 3 TO 5 YEARS TO ENHANCE YOUR GREENHOUSE OPERATION?
18%
Recruitment and training programs
16% 6%
Automation of certain tasks
mechanization are seen as presenting promising opportunities in the coming years for approximately 45 per cent of respondents. Forty-three per cent of respondents see the ‘buy local movement’ as a possible boon for business in the next three-to-five years, while 41 per cent see ‘little to no pesticide use’ and its implications as being an opportunity in the years to come.
In addition to these opportunities, the majority of survey participants, approximately 41 per cent, noted that
Other
None of the above 24% All of the above 16%
Employee retention initiatives
they planned to invest in technology upgrades in their production in within the next five years. Another 37 per cent said they planned to make infrastructure improvements and 20 per cent indicated research and development was their priority investment and 28 per cent said they would be investing in a combination of all three for the next few years.
Greenhouse Canada would like to thank readers who took the time to fill out this year’s grower survey. Winners of gift cards will be notified via email.


Meet BLUERAY RZ , a new long English cucumber variety from Rijk Zwaan for high tech greenhouse growers. Blueray RZ offers superior fruit quality, high yield potential and a labour-friendly open plant structure. The robust root development and strong fruit setting, even in hot summer conditions, make Blueray RZ a strong player for your long English cucumber program. For more information, contact: Rijk Zwaan Canada | John Devries, Cucumber Crop Specialist | j.devries@rijkzwaan.com RZH Canada Ltd. | Max Saad, Director of Sales | max@rzhcanada.ca
www.rijkzwaanusa.com

BY GREENHOUSE CANADA
Can you elaborate on the challenges that cannabis aphids and rice root aphids pose to cannabis crops?
Cannabis aphids (Phorodon cannabis) and rice root aphids pose significant challenges to cannabis crops, impacting yields, plant health, and ultimately, the bottom line for Canadian cannabis growers. The impact of these pests is multifaceted, affecting various growth parameters such as vigour, photosynthetic rate, and plant height, and they become
particularly problematic when winged aphids get caught in the final product. The presence of honeydew and sooty mold, which are byproducts of aphid infestations, have been observed and continues to be a concern.
The impact of cannabis aphids on THC content, in one study conducted by Jason Lemay (2022), showed that there was no effect on THC concentration in one cannabis cultivar, indicating that the primary concern with cannabis aphids might
Niagara College researchers have been working on a number of projects to enhance pest management strategies in cannabis cultivation. Pictured above, students working on a project unrelated to the trials mentioned in this article.
not be on the cannabinoid levels but more on the growth and physical quality of the plants. However, this observation might not extend to all cultivars or to other aspects of plant development and health. On the other hand, a thesis from Eze Pojmann-Ezeonyilo (2022) indicated that Phorodon cannabis reduced hemp bud dry mass and THC and CBD content, highlighting a direct impact on yield and cannabinoid profiles in hemp, which suggests that the impact may vary between hemp and cannabis, or among different cultivars.
The industry has learned much about managing Phorodon cannabis since the legalization of cannabis, adopting strategies like starting with clean stock, quarantining new plants, and employing cultural and physical approaches, including heat treatment during greenhouse sanitation processes. Improved management practices, including the efficient use of biopesticides and the development of a more favourable environment for these products, have made the pest more manageable but it remains a common threat. The introduction of Hop-Latent Viroid (HLVd)
solutions that are both effective against pests and safe for the plants.
free material from tissue culture has also contributed to better pest management. The challenge with rice root aphids has similarly decreased, attributed to preventive and curative approaches, including the use of repetitive biopesticide drenches. There seems to be a buildup of beneficial fungi in the root zones, aiding in the overall reduction of these aphids in the industry. The endophytic capacity of these fungal biopesticides might be impacting the overall reduction of rice root aphids, though the challenge persists in both cannabis and hemp in the U.S. and Canada, becoming a growing issue in nursery crops as well (pers. Comm. Jacob, 2024).
Some of your research has focused on managing these pests as traditional methods have proven ineffective. What














have you and your team discovered about best practices for managing them?
Our research into managing cannabis aphids and rice root aphids, particularly in the context of Canadian cannabis production, has illuminated several key insights and best practices for dealing with these pests. Given the limited pest management options against these pests, for rice root aphids, we and our partners mainly focus on finding key novel products, aiming at achieving higher efficacy and faster results with fewer applications. Most importantly, we wanted to assess the phytotoxicity risk of various products, rates, and number of applications.
The findings from various studies highlight a nuanced approach to pest management that balances efficacy against potential phytotoxic effects. While repeated drench applications of biopesticides can be effective, their concentration and frequency of application need careful consideration to avoid negative impacts on plant growth and yields. New products tested for managing rice root aphids demonstrated more than 90 per cent efficacy in both propagation and vegetative plants. However, these








products also exhibited phytotoxicity on the root zone, highlighting a common challenge in pest management: finding solutions that are both effective against pests and safe for the plants.
An article published in Greenhouse Canada last year, indicated precise environmental controls and careful cultivar selection are key to enhancing biological controls of pests like the cannabis aphid, can you elaborate? The relationship between environmental controls, cultivar selection, and the efficacy of biological controls in managing pests like the cannabis aphid is complex and multifaceted. Our research, conducted in collaboration with Koppert Canada Ltd., assessed the impacts of various combinations of wind speed and relative humidity, on the efficacy of two beneficials, either alone or in combination (Aphidius matricariae and Chrysopa carnea) at reducing cannabis populations on two
different cultivars (cultivars confidential as per the source).
Wind and humidity had a significant impact on the effectiveness of these biological control agents. Specifically, we discovered that the efficacy of beneficial insects was dramatically increased by maintaining lower wind speeds and keeping humidity levels consistent and at higher values. This insight underscores the importance of precise environmental control in greenhouse settings to maximize crop yields, aid in disease management and achieve the full potential of biological pest and disease control methods. For example, if the wind speed exceeds 2 m/s at the plant canopy and RH is lower than 45 to 50 per cent, this severely impacts the efficacy of these parasitoids. Similarly, management of Botrytis bud rot can’t be achieved with just low humidity and more air flow; many other strategies must be implemented, including reduced plant density and spraying with biofungicides
like Rootshield HC at proper timing (Mahmoud et al., 2023).
These conditions not only favour the optimal performance of the beneficial insects but also support a more favourable Vapor Pressure Deficit (VPD) for cannabis growth. This insight is critical as it underscores the importance of precise environmental control in greenhouse settings to maximize the potential of biological pest control methods. Recent publications on Botrytis bud rot disease management (Simon Fraser University, with collaborators) provide many other insightful strategies (eg. flower shape, plant density, sprays of Rootshield HC, etc.) but finding the right balance in steady humidity levels at critical times for both pests and diseases is important.
Our research also explored the role of cultivar selection in pest management, particularly focusing on the differential susceptibility of cannabis cultivars to aphid infestation and disease. Although

We’re growing our assortment to continue to serve you!
New programs for next year: Dahlia Tubers, Vegetative Cutting Dianthus, Lily Bulbs, and Tulip Bulbs. And, we’ve added dozens of great, new varieties to our existing programs.
InFlora™ Cut Flowers represents a dedicated team of breeding, technical support, and industry experts that connects cut flower growers to the optimal varieties, product forms, supply chain, and growing recommendations.


The InFlora™ Cut Flowers team along with our strategic suppliers created an assortment optimized based on your production location. These strategic suppliers include leaders in the cut flower market: Syngenta Flowers, Danziger, Sakata, Kapiteyn, Evanthia, Headstart Nursery, HilverdaFlorist, Kubepak, Raker-Roberta’s, PanAmerican Seed, UNEX, and VWS. This avant-garde group is excited for you to get to know our capabilities and the varieties we represent.















specific details about the cultivars remain confidential, our findings revealed differences in pest and disease dynamics between indica and sativa commercial cultivars. For example, from an initial inoculation of three aphids per plant, one cultivar experienced an 8-12-fold increase in aphid population within four weeks, while the other exhibited a higher susceptibility to powdery mildew. These results highlight the complex interactions between cultivars, pest populations, and disease incidence. Selecting cultivars that are less attractive to pests can reduce the burden of pest management and improve efficacy of biological control agents.
Can you share details on some of the targeted root/soil treatments in controlling rice root aphids your team looked into?
Our team has explored various targeted root and soil treatments to control rice root aphids in cannabis cultivation, considering the balance between efficacy against the pest and safety for the plants. To briefly summarize our overall findings, there are three main things to look at.
Efficacy vs. Phytotoxicity: Finding

a balance between controlling the pest and avoiding harm to the plant is crucial. Our trials suggest that while certain biopesticides and treatments can be effective, they may also pose risks to plant health if not applied judiciously.
balance between controlling the pest and avoiding harm to the plant is crucial.
Environmental conditions: The effectiveness of soil treatments can be influenced by the growing conditions, including soil type, moisture levels, and other environmental factors. Optimizing these conditions can enhance the efficacy of treatments and support plant health.
Integrated Pest Management (IPM): Root and soil treatments should be part of a broader IPM strategy that includes biological controls, environmental management, and selection of cultivars more


unfavourable to pest levels. This holistic approach can help manage pest populations more effectively and sustainably.
How might the findings of this study impact the broader cannabis industry in terms of yield improvement and reduction of crop losses?
The findings from our studies on pest management in cannabis cultivation, particularly focusing on aphids and root aphids, have significant implications for the broader cannabis industry, especially in terms of yield improvement and reduction of crop losses. Here’s how our research could impact the industry:
Filling Knowledge Gaps: Our research contributes to filling the substantial knowledge gaps in the cannabis industry regarding pest management. By systematically investigating novel solutions for pests like the cannabis aphid and rice root aphid, as well as testing various control measures, we provide data-driven insights that can inform more effective pest management strategies. While our studies have added valuable information, there remains much to explore and understand about pest dynamics in cannabis cultivation.
Encouraging Collaboration and Open Sharing: Sharing findings and collaborating openly with IPM companies, researchers, and students is critical for the advancement of the cannabis industry. By fostering a culture of openness about challenges and successes, the industry can collectively advance more robust and sustainable pest management strategies.
Exploring New Research Avenues: Our interest in further studies, such as investigating the effects of Herbivore Plant Induced Volatiles (HIPVs) on beneficial insects and pests, and conducting efficacy trials on other predators like Anystis, mirids, and nabids, in collaboration with other research groups already investigating these, points to the potential for broadening the scope of pest management research in cannabis.
Impact on Yield Improvement and Crop Loss Reduction: By enhancing our understanding of pest management in cannabis and identifying effective strategies for controlling pests like aphids, our research can help reduce crop losses and improve yields. Effective pest management not only protects the plants from damage but also ensures the quality of the cannabis product, which is crucial for both medical and recreational markets.



The search is underway for Greenhouse Canada’s Top 4 Under 40. Nominees must work in the Canadian greenhouse, horticulture industry or allied trades and be 39 years of age or younger by Dec. 31, 2024.

Know someone who is a standout leader in the industry who exemplifies the spirit of innovation, growth and forward-thinking? Someone with an unmatched passion and dedication to their craft and its future? Tell us! Nominate a supervisor, staff member or fellow grower to recognize their impact on the farm and on the Canadian greenhouse sector.

NOMINATIONS CLOSE MAY 10, 2024

BY DR. MOHYUDDIN MIRZA
This is a busy season for bedding plants and ornamental growers and as plants grow and mature so too do problems. I always find that the fault lies with our crop management practices and not with plants. Plants are totally dependent on how you provide for their needs.
I am sure growers know very well that plants need certain essential elements to grow and prosper but we forget that plants are non-selective, meaning that they will absorb nutrients inputted in the root zone. Plants are also smart in that they choose what they need at what time. For example, they will absorb more nitrogen when in a vegetative state and more potassium when flowering and fruiting. Under high temperature conditions, plants can selectively absorb water to meet their transpiration needs and leave the nutrients in the root zone.
That is why the plant’s Electrical Conductivity (EC) increases in summer. So, the basic needs are:
• Carbon, hydrogen and oxygen. Carbon dioxide from air and hydrogen and oxygen from water.
• Then nutrients, nitrogen, phosphorus, potassium, calcium, magnesium, sulfur which are labelled as macro-elements, meaning they are needed in 100 to 300 mg/L. Then we have micro or trace elements which include iron, manganese, copper, zinc, boron, molybdenum, chloride and silicon.
ABOVE
• Then plants need water with or without fertilizer. Energy is needed to transport that water from root zone to leaves and then released into the air and nutrients are kept in the leaf cells for making other products.
• Any one of the nutrients can become the limiting factor if not supplied in optimum amounts.
• In the greenhouse plants needs proper day and night temperatures, and relative humidity. High or low temperatures affect the uptake of nutrients and water.
• The pH of the root zone ultimately controls the uptake of nutrients and it is one of the most complex aspects of management. For crops grown in soilless growing medium, a pH of between 5.8 and 6.2 is recommended. The plants themselves change the pH to alkaline side when growing vegetatively which reduces the uptake of some trace elements. The pH on acidic side increases the uptake of some trace elements which results in toxicity.
As growers you should be aware of the plant’s need in general and specific in some cases. For example, peppers need higher boron levels and poinsettias need higher molybdenum.
A grower sent me pictures (Images 1 and 2) of some very unwell petunias as well as some lophospermum (Image 3) and wanted to know
A crop of petunias with many tiny, white spots which could be due to a pH of 5.5. Spray damage was ruled out.
This image shows the petunia plants (from Image 1) a little further along in their growth. A few lower leaves show whitish spots and it seems like they have recovered but their tops are showing typical calcium deficiency
This picture of lophospermum shows a sudden collapse of plants which happens when roots are not able to meet the transpiration demand of the leaves.
what had happened. The information provided at the time indicated a pH of 5.5. This is my analysis of the issue:
• In picture 1, there are many tiny, whitish spots which could be due to a pH of 5.5. Spray damage was ruled out.
• On closer examination, I found that there were signs and symptoms of edema, where cells burst open due to root pressure and sudden drop in night temperature. It can also happen when sunny days are followed with cloudy, cold and high humidity days.
• Root pressure happens when irrigation is done late in the day. Watering should be done two hours before sunset.
• In picture 2, the petunias are more advanced than what is shown in picture 1. There are few lower leaves showing whitish spots and seems like plants recovered but tops are showing typical calcium deficiency.
• Picture 3 of lophospermum shows a sudden collapse of plants. This happens when roots are not able to meet the transpiration demand of the leaves. It can happen when cloudy weather is followed by bright, sunny days. Grower should have been able to take actions proactively. pH should be monitored regularly and trends predicted and adjustments should be done before any damage is visible. The grower could have used the following table for decision making at the right time.
• Picture 4 shows a very vegetative pepper plant due to lower 24 hours average temperature. Night temperature was dipping to 16C°. Internodal stretch is evident. This pepper crop was being grown with tomatoes, so both tomatoes and peppers were grown at similar climate parameters.



Your local Plant Products representative is always available to provide industry-leading technical support.
Everything you need to grow
Plant Products is a distributor of fertilizer, biocontrols, crop protection, and other innovative inputs serving the Canadian specialty horticulture industry for over 80 years.
• Picture 5 is of the same crop and pepper fruit is shrivelled due to not enough food being sent to the fruit and fluctuations in temperature and humidity and also no supplemental CO2
• Picture 6 shows a good, well-balanced crop, grown at proper temperature, relative humidity, and supplemental CO2
In this case, the grower should have paid close attention to climate conditions so that plants did not stretch and fruit development is proper. Early fruit is generally sold at better prices and an economic loss is possible.
If you want to learn about proper temperature and other crop management practices, please refer to Greenhouse Canada November, December 2023 and
Image 4 shows a very vegetative pepper plant due to lower 24 hours average temperature. Image 5 shows a pepper crop where not enough food is being sent to the fruit and fluctuations in temperature and humidity are impacting fruit
January 2024 editions. I have covered cucumbers, tomatoes and peppers programs.
Dr. Mohyuddin Mirza is a greenhouse industry consultant in Alberta. drmirzaconsultants@gmail.com


GAP analyses help identify opportunities for improvement in workplace safety programs.

Favourites from Guelph University’s 2023 perennial trials
BY RODGER TSCHANZ
Perennials in the Ontario Perennial Trial (run by the University of Guelph and Landscape Ontario) are evaluated for at least three growing seasons. Bloom performance and winter survival are two of the primary observations that are made during that period. The perennials presented in the following article represent some of the favourite plants chosen by visitors to the trials in the late summer and early fall. The early season bloomers in this list are some of my personal favourites based on performance during the time of year when there are few visitors to the trial garden.
We had more than 40 different echinacea cultivars planted in the trial in 2023. All bloomed the first year to varying degrees, but we are anticipating a great bloom display in the 2024 growing season with all the trial entries on the same bloom cycle. That said, one colour jumped out as a favourite of visitors in August of 2023 and that was Double Scoop Watermelon Deluxe echinacea (Image 1) from Darwin Perennials.



















A new greenhouse dedicated to research and innovation at Niagara College Canada’s Daniel J. Patterson campus (Niagara-on-the-Lake). This new greenhouse will feature controlled temperature, humidity, lighting and CO² in various growing environments, five individually contained bays, dedicated horticulture and postharvest laboratories, and vertical grow room.

























Propagated in tissue culture, this sturdy, compact plant has a dusky, dark pink double petals.
Other echinacea cultivars that caught visitor’s attention included MOOODZ Jealousy (Image 2) from HilverdaFlorist. This cultivar is propagated from tissue culture as well; it is compact with a light-green coloured single bloom. Panama Red (Image 3) from ThinkPlants/ Danziger is propagated from cuttings. It is well branched and produces many bright red blooms in its first year.
Eyecatcher Coral Craze (Image 4) from Proven Winners, Artisan Red Ombre (Image 5) from Kieft and Pollynation Yellow (Image 6) from Benary are other compact cultivars that caught the attention of trial visitors in their first year of planting.
Salvia yangii, better known as Perovskia or Russian sage is represented in the trials by a
steady trickle of new releases of dwarf forms over the last five years. Jelena (Image 7) from Dümmen Orange is one of those cultivars that is vegetatively propagated. It has a compact habit, is highly branched and is covered in pollinator friendly blue flowers in the late summer. This was popular with the trial visitors in 2023 and is an excellent choice for both container and landscape applications where space is limited. Our trial specimens were planted in 2022.
Rudbeckia fulgida var. sullivantii Goldblitz (Image 8) is a seed propagated cultivar available from Kieft. Our trial specimens were planted in 2022. In the greenhouse, this rudbeckia is known for its ability to bloom first year without special lighting treatments. It is earlier to finish than the traditional Goldsturm. In the field, this selection can reach heights of





70 cm. In our trials it began blooming in early July and continued through until late October when we had our first frost.
The interspecific hybrid Rudbeckia American Gold Rush (Image 9) also put on a tremendous show in 2023. It’s approximately 10 cm shorter than Goldblitz and is vegetatively propagated. The bloom period runs from early July to late October. It was the Perennial Plant of the Year for 2023 and was an AAS perennial winner in 2020. This selection appears to be highly resistant to Septoria leaf spot. American Gold Rush from

ThinkPlants/Danziger was planted in the trial in 2022 as well as in 2023.
The hardy hibiscus selection, Summerific Evening Rose (Image 10) from Proven Winners has large showy pink flowers and reddish foliage. Our trial specimens were planted in 2020 and continues to shine. Voted a favourite by the 2023 visitors.
Dwarf buddleia cultivars are starting to become available. In some jurisdictions, Buddleia or butterfly bush is seen to be invasive although the new buddleia breeding that has been


submitted to our trial program has not shown any invasive tendencies and in fact appear to be sterile. That means they also have a long season of bloom production. One of these, Chrysalis Pink (Image 11) from Darwin Perennials, was planted in 2023, bloomed throughout the season and was selected as a favourite by garden visitors. This is a great choice for containers as well as the landscape.
It is hard to keep track of all the new lavenders that are hitting the market.
LaDiva Berry Beautiful (Image 12) from Dümmen Orange and Laveanna Grand Purple (Image 13) from ThinkPlants/ Danziger were both planted in 2023 and both received votes of appreciation from garden visitors. Both specimens were planted in 2023 so overwintering ability on these Spanish lavender types has yet to be tested at our site.
Coreopsis Super Star and UpTick Gold & Bronze (Images 14 and 15) are two newer selections from Darwin Perennials. In 2023 both were selected as favourites by visitors to the gardens. Both have large flowers and great bloom performance. Flowering was at its peak in August for these newly planted specimens.
































Polemonium pulcherrimum or Jacob’s ladder grows well in shady parts of the garden. Add some variegated gold foliage and this selection positively glows in shady areas. Such is the case for Golden Feathers (Image 16) another 2023 trial entry from Darwin Perennials. When it blooms in the spring, it has purplish flowers. Its compact habit and attractive foliage stand out on the garden centre bench as well.
Agastache Sunny Sparks Pink Improved (Image 17) from ThinkPlants/ Danziger (planted in 2022) received attention on Open House Day. Any pollinator garden would benefit from including agastache as it is a magnet for bees and other pollinators. This selection has excellent bloom coverage and season long bloom performance.
The downside to having an open house in August is that all the early season blooming perennials are usually past their peak and visitors don’t vote for them as a result. In the next section I want to highlight a few of these plant groups that brighten up the spring and early summer gardens.
Pulsatilla vulgaris Prime Papagena (Image 18) is a mixed colour seed offering of pasque flower from Jelitto that shows well for spring garden centre offerings; in the garden it is at its peak in late April. Our trial specimens were planted in 2020 in full sun and have remained early season stunners for that period.
The Decadence series of baptisia is available in approximately ten different colours from Proven Winners. We planted six of those in 2020. Cherry Jubilee and Vanilla Cream (Image 19) have stood out as the most vigorous growers of the six and have established in the trials to provide an incredible floral display in June.
This year, the University of Guelph Flower Trials can be veiwed during Landscape Ontario’s Open House at its location in Milton at 7856 Fifth Line South, on August 15 from 9 a.m. to 1p.m.



GARY JONES | greenhousewolf@gmail.com
You know the conversation at a party, or when having new people over for dinner. ‘So, what do you do?’ (I know it’s interesting to find out, but does what we do actually define who we are? I guess that’s a different conversation.) If asked that question, and I answer along the lines of ‘I work in the greenhouse industry’, I invariably get back either some derogatory comment about ‘destroying farmland’, or, more often, ‘Oh, so you must grow cannabis!’ (Incidentally, I’ve never had anyone say ‘thank you for helping with providing delicious local produce, beautiful flowers for my home, or fabulous plants for my garden’. Anyway, that gripe over, let’s move on…). Responses like those remind me to see them both as great ‘teaching moments.’
Last week, my wife and I were shopping at a large, well-known big-box store. Not our favourite, but we ventured to the ‘garden and seasonal’ section.
We happened upon a display cart packed with
beautiful rose bush at that price. I’m somewhat enabling ‘Mr. Big Box’ to justify their silly pricing to the grower, who is the one carrying the costs of all the inputs, production time and risk.
Skip forward three days, and this week I have been enjoying the opportunity to visit a daughter and her family in Ohio. When we arrived, I enthusiastically said how much I loved the vase of mixed flowers on the kitchen countertop. To which she replied, even more enthusiastically, ‘Yes, aren’t they so lovely – just $1.49 on sale at the grocery store!’ That wasn’t a typo – I did mean to write $1.49. Even when converted from US$, it’s still obscenely cheap, right? Despite my years of teaching my kids, it sadly seems that not even they are immune to equally betraying the industry, just like I had done a few days previously.
‘What can we do about the pricing we see on our products in store?’
containerized garden rose bushes. The plants were dormant, clearly hard (and nicely) pruned, but the brightly coloured tags caught our eye. Then too did the price tag - $17.49. My favourite perennial garden flower, well pruned, and looking full of promise. How could I – we - say no to a new addition to our rose garden? And besides, it was our wedding anniversary, so no excuse, and a treat for both of us that should last a good few years. (Wedding anniversary shopping trip to a Big Box –who says romance is dead?)
I really like to support our local family-owned garden centres, but at this price, the impulse purchase was already in the cart, while I fought back pangs of guilt and betrayal against my industry.
Once back in the car, I then had a rant to my wife along the lines of ‘how on earth can they (the store) sell plants that have had so much time, energy and inputs into them for that kind of price – they’re destroying the industry!’ I know (some of) the answers to that. But then I realized that I should take some (not all – let the retailer carry their share too!) of the blame for buying the (hopefully)
So, I’ve been left with some concerns. Firstly, perhaps we can get some wonderful ad agency to come up with a campaign that will instantly re-focus the public’s perception of ‘the greenhouse industry’. A perception that changes the answer to the opening social question above to make people respond in the knowledge that ‘greenhouses’ (also) mean nutritious, fresh, local food for the body, and beautiful flowers to nourish the mind and soul. It also means highly efficient use of agricultural land and resources such as water, fertilizers, and energy. And biological pest control with few toxic chemicals.
Secondly, what can we do about the pricing we see on our products in store? Admittedly, the two examples given may not be that common. But they do reflect a lack of respectful valuation of the time, energy, and expertise that those employed in the greenhouse industry have dedicated their work lives to. In terms of ‘teaching moments’, it seems we have a lot of opportunities and work to do.
And in case you’re wondering. I expected my daughter’s $1.49 flower ‘sale’ bouquet to have quit after a couple of days. But it’s still looking just great after a week. I’m somewhat conflicted about that to be honest.
Gary Jones sits on several greenhouse industry committees in BC and welcomes comments at greenhousewolf@gmail.com.


